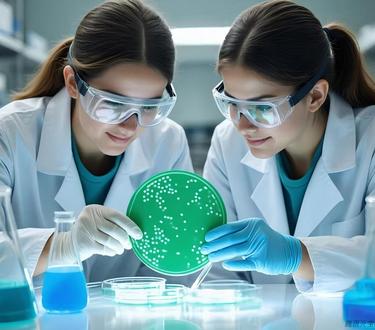
微生物检测

从种养环境、原材料到生产、流通、消费环节,全过程提供检测检验、工艺及技术研发、咨询及培训等服务。


Service Background

农药残留检测
农药残留(Pesticide residues),是农药使用后一个时期内没有被分解而残留于生物体、收获物、土壤、水体、大气中的微量农药原体、有毒代谢物、降解物和杂质的总称。它们残留在粮食、蔬菜、水果、鱼、虾、肉、蛋、奶中,造成食物污染,人们通过食用进入体内,危害人的...
查看更多 →

兽药残留检测
兽药残留是指动物产品的任何可食部门所含兽药的母体化合物及 或其代谢物,以及与兽药有关的杂质残留。目前对人畜危害较大的兽药残留有:抗生素类、磺胺类、呋喃类、抗寄生虫类、激素类等。人类长期摄入含兽药的动物性食品后,药物不断在人体内蓄积,当积累到定程度后,...
查看更多 →

食品添加剂检测
食品添加剂是食品加工制造过程中合理使用,为改善食品色、香、味等品质,以及防腐和保鲜等作用而加入的人工合成或者天然物质,被誉为现代食品工业的灵魂。但是违规滥用食品添加剂或添加非食用违禁物质,会影响人类身体健康。为保障消费者食品安全,加强食品添加剂规范管...
查看更多 →
微生物检测
食品微生物检验是衡量食品卫生质量的重要指标之一,也是判定被检食品能否食用的科学依据之一。通过食品微生物检验,可以判断食品建工环境及食品卫生情况,能够对食品被细菌污染的程度作出正确的评价。在食品安全中,微生物引发的食源性疾病仍是我国头号食品安全问题。
查看更多 →

元素检测
在现代工业和科研领域,微量元素的精确检测对于确保产品质量和推动科学研究至关重要。我们提供全面的微量元素检测服务,涵盖重金属、贵金属、全属元素、非金属元素以及阴阳离子等多种检测项目。我们的检测范围广泛,包括但不限于铅、镉、铬、铜、锌、铁、铝、钾、钠、钙...
查看更多 →

营养成分检测
食品营养标签主要是以一种标签形式显示在食品的外包装上,向消费者透明化地公开食品中的营养显示食品中所包含的营养成分, 具有健康声明和营养声称的作用,能够使消费者更加客观、理性地选购相关食品产品。为了保证食品生产、销售的有序性、合理性,规定食品企业在中国境...
查看更多 →

非食用物质检测
非食用物质是指添加到食品中的非食品用化学物质和其他可能危害人体健康的物质。根据相关法律、法规、标准的规定,非法添加物不是传统上认为的食品原料,同样也不属于国家批准食用的新资源食品和卫生部公布的药食同源或作为普通食品管理的物质。在食品中添加非食用物质是...
查看更多 →

基因及过敏原检测
振兴检测以科学严谨为基石,提供全面的基因及过敏原检验检测服务。我们涵盖动物源性、植物源性、转基因及过敏原成分检测,确保食品来源安全透明,原料纯正健康,保障消费者知情权。振兴检测,以市场需求为指引,以科技进步为动力,为食品行业提供卓越服务,让消费者吃得...
查看更多 →

标签标识检测
振兴检测提供食品标签“审核 + 制作 + 检测” 一体化解决方案,服务内容包括预包装食品、普通食品、特殊食品。保健品、食品新原料、食品添加剂等,我们以国家标准为核心依据,从标签设计初筛到成品检测全程把控,助力企业确保标签内容合规精准,全方位提升产品市场...
查看更多 →
Service Advantage
Qualification Inspection
资质检测
国家认可实验室资质,检测报告权威可靠
Professional Team
专业团队
专业技术团队,检测经验丰富
Advanced Equipment
先进设备
先进仪器设备,检测数据精准
Stable Service
服务稳定
标准化管理体系,服务质量稳定
Diversified Demands
需求多样化
一站式检测解决方案,满足多样化需求
Service Process
业务咨询与 需求确认
签订检测协议
样品接收与 登记
检测方案制定
实验室检测分析
数据审核与 报告编制
报告交付与 归档
后续技术咨询